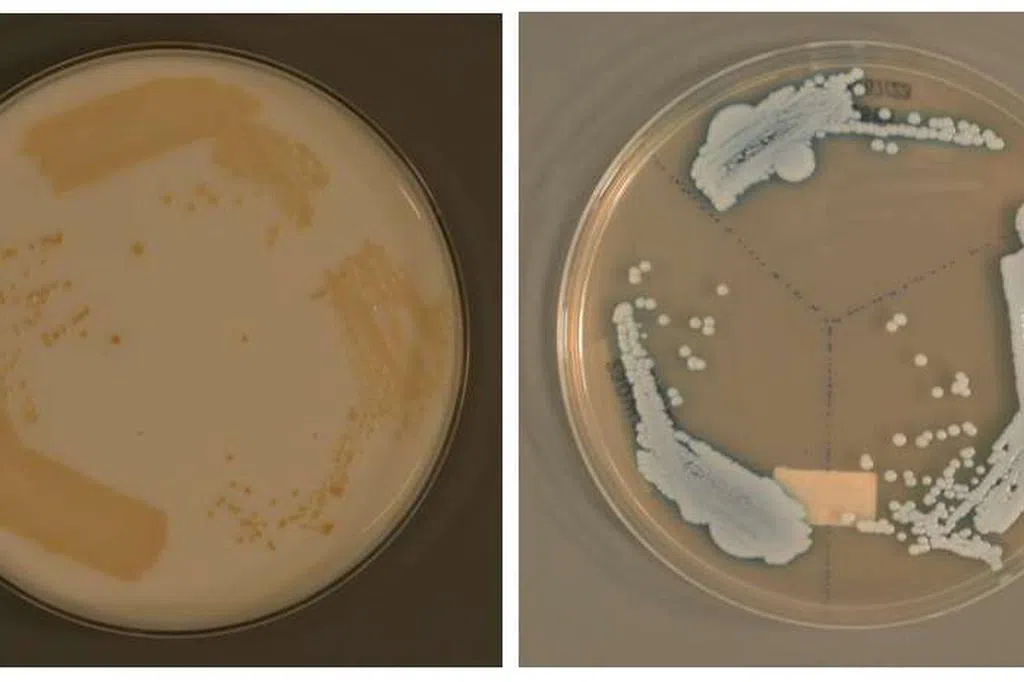

本地医疗研究团队取得重大突破,把酵母培养成“最佳药剂师”,服用后可在人体内自动制药并调节剂量,既提升药效,也降低副作用。这一成果为精准医学的发展带来新的可能。
一般情况下,医生会根据病情,开出固定剂量的药物,患者须定期复诊,以评估药效和调整剂量。但人体对药物的反应可能难以预测,若能实时评估并即时调整剂量,治疗效果将大幅提升。
新加坡国立大学杨潞龄医学院星期一(12月16日)发文告说,研究团队通过生物工程技术,让酵母菌(yeast)具备“药剂师”功能,在人体内自动调节药物剂量。
这项创新突破与现有的微生物科技(Microbial biotechnology)不同,后者多集中在单细胞生物的应用,国大团队则是把酵母菌,大量繁殖成微生物群落(Microbial Communities),以具备更复杂的功能。
研究员针对个别病患的病情,设计出不同功能的酵母菌,让病患口服。酵母菌进入人体消化道后,可根据体内的疾病标志物,自动制药并调整剂量。
当致病成分较多时,酵母菌会自动增加药物产量;反之,若致病成分减少,酵母菌会降低剂量,直到病情痊愈、致病成分完全清除。
这意味着,病人服用酵母菌后,能即时获得所需的精准药物剂量,避免剂量过多或过少的问题。
国大合成生物学临床与技术创新中心与杨潞龄医学院合成生物学转化研究中心和生物化学部门主任张旭副教授说:“这种人工改造的智能酵母,可以彻底改变控制微生物群落的方式。群落独立分裂成不同类型的细胞,因此可以分工合作,减轻细胞的负担。”
酵母菌的副作用少,通常在一周至两周后会通过消化系统排出体外。然而,对酵母过敏的病患,不适合使用这种治疗方法。
这项研究正处于概念验证(proof of concept)阶段,还须进行更多测试,预计多年后才能广泛使用。下一步,研究团队将继续优化酵母菌如何根据不同疾病标志物做出精准反应,并进一步探索利用酵母菌治疗特定疾病的可行性。